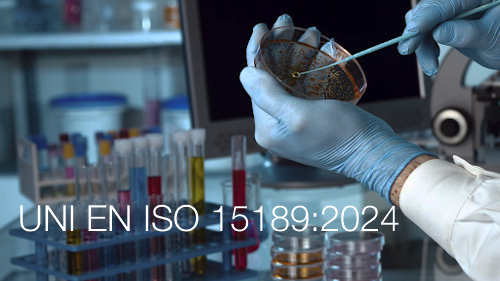
UNI EN ISO 15189 2024

UNI EN ISO 15189:2024 | Laboratori medici - Requisiti qualità e la competenza
| ID 22149 | | Visite: 6358 | News Normazione | Permalink: https://www.certifico.com/id/22149 |
UNI EN ISO 15189:2024 | Laboratori medici - Requisiti qualità e la competenza
ID 22149 | 30.06.2024 / In allegato Preview
UNI EN ISO 15189:2024 Laboratori medici - Requisiti riguardanti la qualità e la competenza
La norma specifica i requisiti riguardanti la qualità e la competenza per i laboratori medici. Questo documento è applicabile ai laboratori medici nello sviluppo dei loro sistemi di gestione e nella valutazione della loro competenza. È inoltre applicabile per la conferma o il riconoscimento della competenza dei laboratori medici da parte degli utenti del laboratorio, delle autorità di regolamentazione e degli enti di accreditamento.
Data entrata in vigore: 27 giugno 2024
Sostituisce: UNI EN ISO 15189:2023
Recepisce: EN ISO 15189:2022, EN ISO 15189:2022/A11:2023
Adotta: ISO 15189:2022
_______
Il documento che specifica i requisiti di qualità e competenza nei laboratori medici, è applicabile ai laboratori medici nello sviluppo e implementazione dei loro sistemi di gestione e nella valutazione della loro competenza. È, inoltre, applicabile come riferimento per confermare o riconoscere la competenza di tali laboratori da organismi di valutazione di terza parte, autorità di regolamentazione e organismi di accreditamento. Infine, è applicabile anche alle analisi decentrate (POCT Point-Of-Care-Testing).
La nuova UNI EN ISO 15189 rappresenta l’unico riferimento riconosciuto in tutto il modo per la gestione completa – in qualità e in conformità alle disposizioni regolamentari- delle attività dei laboratori medici. Il suo obiettivo è quello di promuovere la fiducia di coloro che si si rivolgono a queste strutture, attraverso l’implementazione e l’attuazione di un sistema di gestione che affronti i rischi e colga le opportunità di miglioramento.
In un numero sempre maggiore di paesi europei, si sta diffondendo come requisito cogente. In Italia, alcune autorità locali hanno iniziato a richiedere ai laboratori che siano accreditati secondo tale norma, per poter operare per conto del sistema sanitario pubblico.
Tutti i laboratori medici dovranno essere conformi alla ISO 15189:2022 a partire dal 7 dicembre 2025. ILAC (International Laboratory Accreditation) ha infatti fissato, e EA (European co-operation for Accreditation) ha ratificato, un periodo di tre anni per la transizione degli accreditamenti dei laboratori la cui attività rientra nel campo di applicazione del Regolamento CE 765/2008.
La nuova norma ISO 15189:2022 è stata preparata dal Comitato Tecnico ISO/TC 212, Clinical laboratory testing and in vitro diagnostic test systems, in collaborazione con il Comitato Tecnico CEN/TC 140 In vitro diagnostic medical devices del Comitato Europeo di Standardizzazione (CEN), in linea con l’Agreement di cooperazione tecnica tra ISO e CEN (Accordo di Vienna).
Il documento presenta importanti novità relative alla valutazione dell’adeguatezza gestionale e tecnica del laboratorio rispetto all’intero ciclo delle sue attività. Nello specifico tratta le responsabilità della direzione e le competenza del personale; l’adeguatezza dei locali, delle strutture e delle attrezzature, compresa la taratura e la riferibilità metrologica di queste ultime; la gestione dei reagenti e dei materiali di consumo; le fasi che precedono e che seguono le analisi, e cioè le fasi di prelievo, manipolazione, trasporto e conservazione dei campioni; i processi di validazione, esecuzione e verifica dei metodi utilizzati per effettuare le analisi; la riferibilità metrologica dei risultati, la loro comunicazione e il riesame; un sistema di gestione capace di assicurare il regolare e coerente soddisfacimento di tutti i requisiti.
Il documento sviluppa gli argomenti, facendo anche riferimento ai requisiti di altre norme internazionali, che diventano, pertanto, parte integrante del sistema di gestione.
Infine, questa nuova versione presenta le relazioni concettuali con i contenuti della ISO 9001:2015, per facilitare l’implementazione di un sistema di gestione, e con i contenuti della ISO/IEC 17025:2017, per facilitare il processo di accreditamento dei laboratori.
...
Fonte: UNI
Collegati
| Descrizione | Livello | Dimensione | Downloads | |
|---|---|---|---|---|
| Previeew UNI EN ISO 15189 2024.pdf |
2105 kB | 2 |